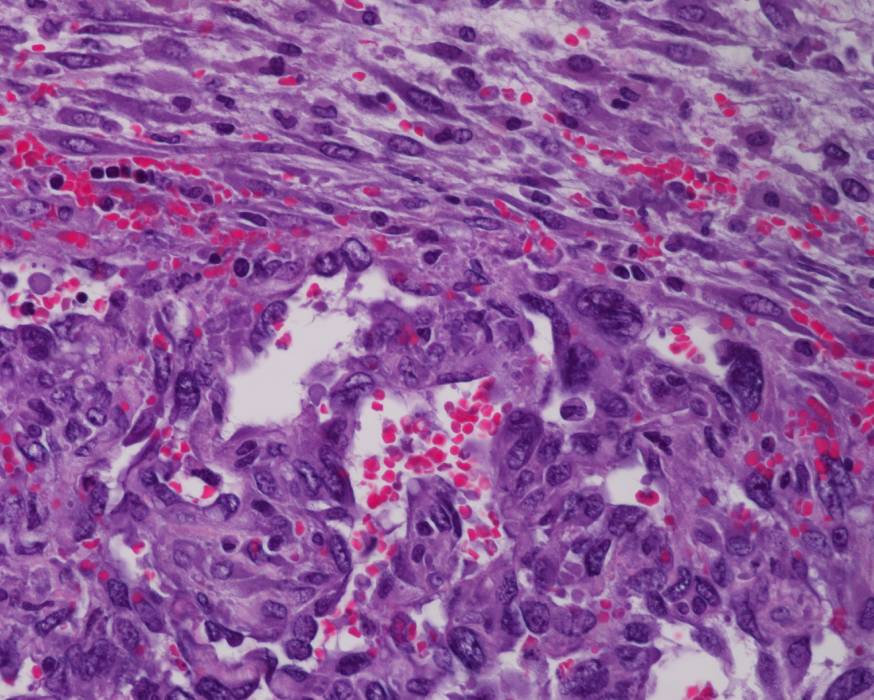

The Hanna Lab group ❤️

Our lab studies malignant vascular sarcomas including angiosarcoma and EHE. These are rare cancers arising from the endothelium or cells which line blood and lymphatic vessels.
We aim to
- Discover the genetic drivers and critical microRNAs involved in the development of vascular sarcomas.
- Identify the key mediators of the metastasis of vascular sarcomas.
- Design and evaluate precision therapeutics to benefit patients of this devastating and understudied disease.